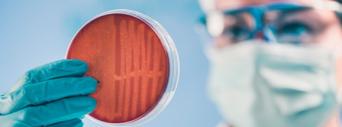
De acordo com estimativas do governo britânico, 700 mil pessoas morrem anualmente por causa de infecções

Recomendados
VCMH/IESS: A importância do indicador para a gestão de custos com planos de saúde
O custo da assistência à saúde segue uma dinâmica própria, distinta da inflação geral da economia. Enquanto indicadores inflacionários como o IPCA capturam a variação média de preços de um conjunto de itens em determinada localização geográfica, o setor de saúde suplementar é imp...
Leia mais…
TEA na saúde suplementar: decisão do STJ cria oportunidade para retomada do foco...
Leia mais…
Plano odontológico: desejo da população e estratégia empresarial caminham juntos...
Leia mais…